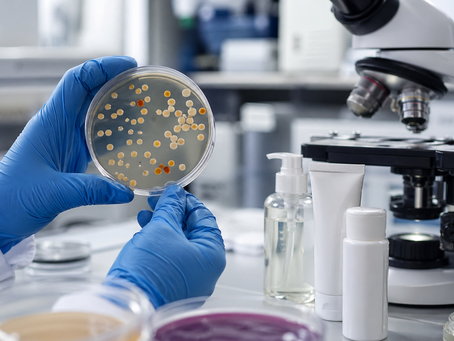
Segurança microbiológica em cosméticos: exigências e testes laboratoriais

top of page


Avaliação de Claims Cosméticos: Fundamentos Científicos, Regulamentação e Metodologias de Comprovação.
O mercado cosmético contemporâneo é marcado por intensa inovação tecnológica, diversificação de portfólio e crescente exigência por transparência científica. Consumidores cada vez mais informados demandam não apenas produtos eficazes, mas também evidências que sustentem as promessas estampadas nos rótulos.
Keller Dantara
15 de fev.7 min de leitura


Determinação de Vitamina C em Séruns: Fundamentos Analíticos, Desafios Tecnológicos e Relevância Científica.
A vitamina C, quimicamente conhecida como ácido ascórbico, ocupa posição de destaque na interface entre ciência, saúde e indústria cosmética. Reconhecida por seu papel essencial na biossíntese de colágeno, na modulação do estresse oxidativo e na proteção contra radicais livres, essa molécula tornou-se um dos ativos mais estudados e utilizados em formulações dermatológicas, especialmente em séruns faciais de uso tópico.
Keller Dantara
14 de fev.7 min de leitura


Antocianinas: o que são, benefícios e onde são encontradas (Guia Completo)
Nas últimas décadas, a busca por compostos bioativos com potencial funcional tem se intensificado em diversas áreas do conhecimento, especialmente nas ciências de alimentos, farmacologia, cosmética e nutrição. Nesse contexto, as antocianinas emergem como um grupo de grande relevância científica e tecnológica.
Keller Dantara
14 de fev.7 min de leitura


Microplásticos em Cosméticos: Onde Aparecem e Como Comprovar Clegações “Free From”.
A discussão sobre microplásticos deixou de ser um tema restrito à oceanografia e à gestão de resíduos sólidos para ocupar espaço central nas agendas regulatórias, industriais e científicas. Nas últimas duas décadas, evidências acumuladas demonstraram que partículas plásticas com dimensões inferiores a 5 mm — classificadas como microplásticos — estão amplamente distribuídas em ecossistemas marinhos, águas continentais, solos agrícolas e até na atmosfera. Mais recentemente, est
Keller Dantara
13 de fev.8 min de leitura


Análise de Alergênicos em Fragrâncias: Fundamentos Científicos, Marcos Regulatórios e Desafios Analíticos na Indústria Contemporânea.
A fragrância é um componente essencial de inúmeros produtos de consumo, desempenhando papel determinante na percepção sensorial, na identidade de marca e na experiência do usuário. Perfumes, cosméticos, produtos de higiene pessoal, saneantes, detergentes, velas aromáticas e até embalagens alimentícias incorporam misturas complexas de compostos aromáticos naturais e sintéticos.
Keller Dantara
12 de fev.7 min de leitura


Acrilamida em Alimentos Processados: Formação, Riscos, Monitoramento e Estratégias de Mitigação na Indústria Alimentícia
A segurança dos alimentos processados ocupa posição central nas agendas científicas, regulatórias e industriais contemporâneas. Em um cenário no qual cadeias produtivas são cada vez mais complexas e globalizadas, compostos formados inadvertidamente durante o processamento térmico passaram a receber atenção sistemática de autoridades sanitárias e centros de pesquisa.
Keller Dantara
12 de fev.7 min de leitura


Microesferas em Esfoliantes: Por que Se Tornaram um Alvo Regulatório e Reputacional na Indústria Cosmética.
Durante décadas, as microesferas plásticas foram amplamente incorporadas a formulações cosméticas com finalidades técnicas específicas, sobretudo em produtos esfoliantes faciais e corporais. Pequenas, uniformes e de baixo custo, essas partículas — geralmente compostas por polímeros sintéticos como polietileno (PE), polipropileno (PP) e polimetilmetacrilato (PMMA) — desempenhavam funções mecânicas importantes, proporcionando abrasão controlada e sensação sensorial diferenciada
Keller Dantara
12 de fev.7 min de leitura


Skincare e microplásticos: ingredientes, “claims” e os desafios regulatórios na indústria cosmética contemporânea
A indústria de cosméticos atravessa um momento de inflexão. Se nas últimas décadas o foco esteve majoritariamente voltado à eficácia sensorial, estabilidade e performance dos produtos, hoje a agenda ambiental ocupa posição central nas decisões estratégicas de formulação. Nesse contexto, a discussão sobre microplásticos em produtos de skincare tornou-se um dos temas mais sensíveis para fabricantes, pesquisadores, agências reguladoras e consumidores.
Keller Dantara
11 de fev.7 min de leitura


Controle de Qualidade em Cosméticos Orgânicos: Fundamentos Científicos, Regulamentação e Práticas Analíticas.
Nas últimas duas décadas, o mercado de cosméticos orgânicos deixou de ocupar um nicho alternativo para se consolidar como um segmento estratégico da indústria cosmética global. Impulsionado por consumidores mais atentos à composição dos produtos, à sustentabilidade ambiental e aos impactos socioeconômicos da cadeia produtiva, o setor apresenta taxas de crescimento superiores às de cosméticos convencionais em diversos mercados.
Keller Dantara
11 de fev.7 min de leitura


Microesferas e Resíduos Cosméticos: Impacto no Efluente e Estratégias de Rastreamento Ambiental.
A presença de microesferas plásticas e outros resíduos cosméticos nos sistemas de esgotamento sanitário tornou-se, nas últimas duas décadas, um dos temas mais discutidos na interface entre ciência ambiental, indústria cosmética e gestão de recursos hídricos.
Keller Dantara
11 de fev.7 min de leitura


Como testar microplásticos em cosméticos: desafios analíticos e melhores técnicas laboratoriais
A presença de microplásticos em produtos cosméticos tornou-se, nas últimas duas décadas, um tema central nas agendas científicas, regulatórias e industriais.
Keller Dantara
10 de fev.7 min de leitura


Glitter é microplástico? Alternativas e como validar a mudança de formulação
O debate científico e regulatório em torno dos microplásticos intensificou-se de forma expressiva na última década, impulsionado por evidências crescentes de sua persistência ambiental, capacidade de dispersão global e potenciais impactos ecotoxicológicos. Entre as diversas fontes identificadas, os cosméticos e produtos de cuidado pessoal ocupam posição de destaque por introduzirem partículas sólidas diretamente nos sistemas de esgotamento sanitário, muitas vezes sem etapas e
Keller Dantara
10 de fev.7 min de leitura


Testes de Absorção Cutânea: Fundamentos Científicos, Métodos Analíticos e Aplicações Regulatórias.
A pele humana, frequentemente descrita como a maior estrutura orgânica do corpo, constitui uma interface dinâmica entre o ambiente externo e o meio interno. Sua função como barreira física e imunológica é amplamente reconhecida; contudo, sua capacidade de permitir a passagem seletiva de substâncias químicas transformou-se, ao longo do último século, em objeto de intensa investigação científica.
Keller Dantara
9 de fev.7 min de leitura


Conservantes Cosméticos: Como Validar Eficácia com Base Científica e Regulatória.
A estabilidade microbiológica de produtos cosméticos é um dos pilares da segurança sanitária e da confiança do consumidor. Diferentemente de medicamentos estéreis, a maioria dos cosméticos — cremes, loções, shampoos, maquiagens, séruns — não é produzida em condições de esterilidade absoluta. Ao contrário, são formulações complexas, frequentemente ricas em água, nutrientes orgânicos e compostos naturais, que podem se tornar ambientes propícios à proliferação de microrganismos
Keller Dantara
9 de fev.7 min de leitura


RDCs para Cosméticos Explicadas: Fundamentos Regulatórios, Bases Científicas e Desafios Contemporâneos no Brasil.
O setor cosmético brasileiro ocupa posição de destaque no cenário internacional. O Brasil figura historicamente entre os maiores mercados consumidores de produtos de higiene pessoal, perfumaria e cosméticos, com forte presença de indústrias nacionais e multinacionais, ampla capilaridade de distribuição e crescente diversificação tecnológica.
Keller Dantara
8 de fev.7 min de leitura


Análise de Pigmentos em Sombras: Fundamentos Científicos, Métodos Analíticos e Relevância para a Segurança Cosmética.
A indústria cosmética contemporânea é marcada por intensa inovação tecnológica, crescente rigor regulatório e consumidores cada vez mais atentos à segurança e à transparência dos produtos que utilizam. Entre as diversas categorias de cosméticos decorativos, as sombras para os olhos ocupam posição de destaque, tanto pelo valor agregado quanto pela complexidade de suas formulações.
Keller Dantara
7 de fev.7 min de leitura


Maquiagens contaminadas: principais microrganismos encontrados e implicações para a saúde e a indústria cosmética
O uso de produtos cosméticos, especialmente maquiagens, está amplamente disseminado em diferentes contextos sociais e culturais, sendo parte integrante da rotina de milhões de pessoas em todo o mundo. No entanto, por trás da aparente segurança e estética desses produtos, existe uma preocupação crescente no campo científico e regulatório: a contaminação microbiológica.
Keller Dantara
6 de fev.6 min de leitura


Controle de Alergênicos: Fundamentos Científicos, Regulamentação e Estratégias Integradas de Gestão
A segurança de produtos destinados ao consumo humano — sejam alimentos, medicamentos, cosméticos ou insumos hospitalares — é um dos pilares da saúde pública contemporânea. Entre os diversos riscos associados à produção e ao consumo desses produtos, a presença não intencional de alergênicos ocupa posição de destaque.
Keller Dantara
6 de fev.7 min de leitura


Teste de Ausência/Presença: Quando Utilizar, Fundamentos Científicos e Aplicações Estratégicas no Controle de Qualidade
A avaliação microbiológica e química de produtos, insumos e ambientes constitui um dos pilares da garantia da qualidade em setores regulados, como a indústria alimentícia, farmacêutica, cosmética, hospitalar e ambiental. Entre as diferentes abordagens analíticas disponíveis, o chamado teste de ausência/presença ocupa posição estratégica por sua simplicidade operacional, relevância regulatória e aplicabilidade em contextos de triagem e monitoramento crítico.
Keller Dantara
5 de fev.7 min de leitura

Segurança microbiológica em cosméticos: exigências e testes laboratoriais
A segurança microbiológica de cosméticos ocupa uma posição central na interface entre saúde pública, ciência regulatória e desenvolvimento industrial. Diferentemente de medicamentos, os cosméticos não têm como finalidade tratar doenças; ainda assim, entram em contato direto e frequente com a pele, mucosas e, em alguns casos, áreas sensíveis como olhos e lábios.
Keller Dantara
5 de fev.7 min de leitura
bottom of page
_edited.png)